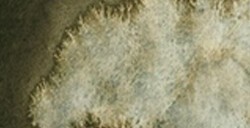
SCHMINCKE HORADAM SUPER GRANULATION FOREST GREY NR. 945

schmincke aquarell-fixativ aerospray
Schmincke Fixierspray für den letzten Schliff bei Aquarellen. Schützt vor Fingerabdrücken, Feuchtigkeit und Staub. Verändert die Farbtöne nicht und verleiht dem Papier Transparenz. Vor Gebrauch schütteln und aus 30-40 cm Entfernung auftragen. Enthält Polyvinyl.